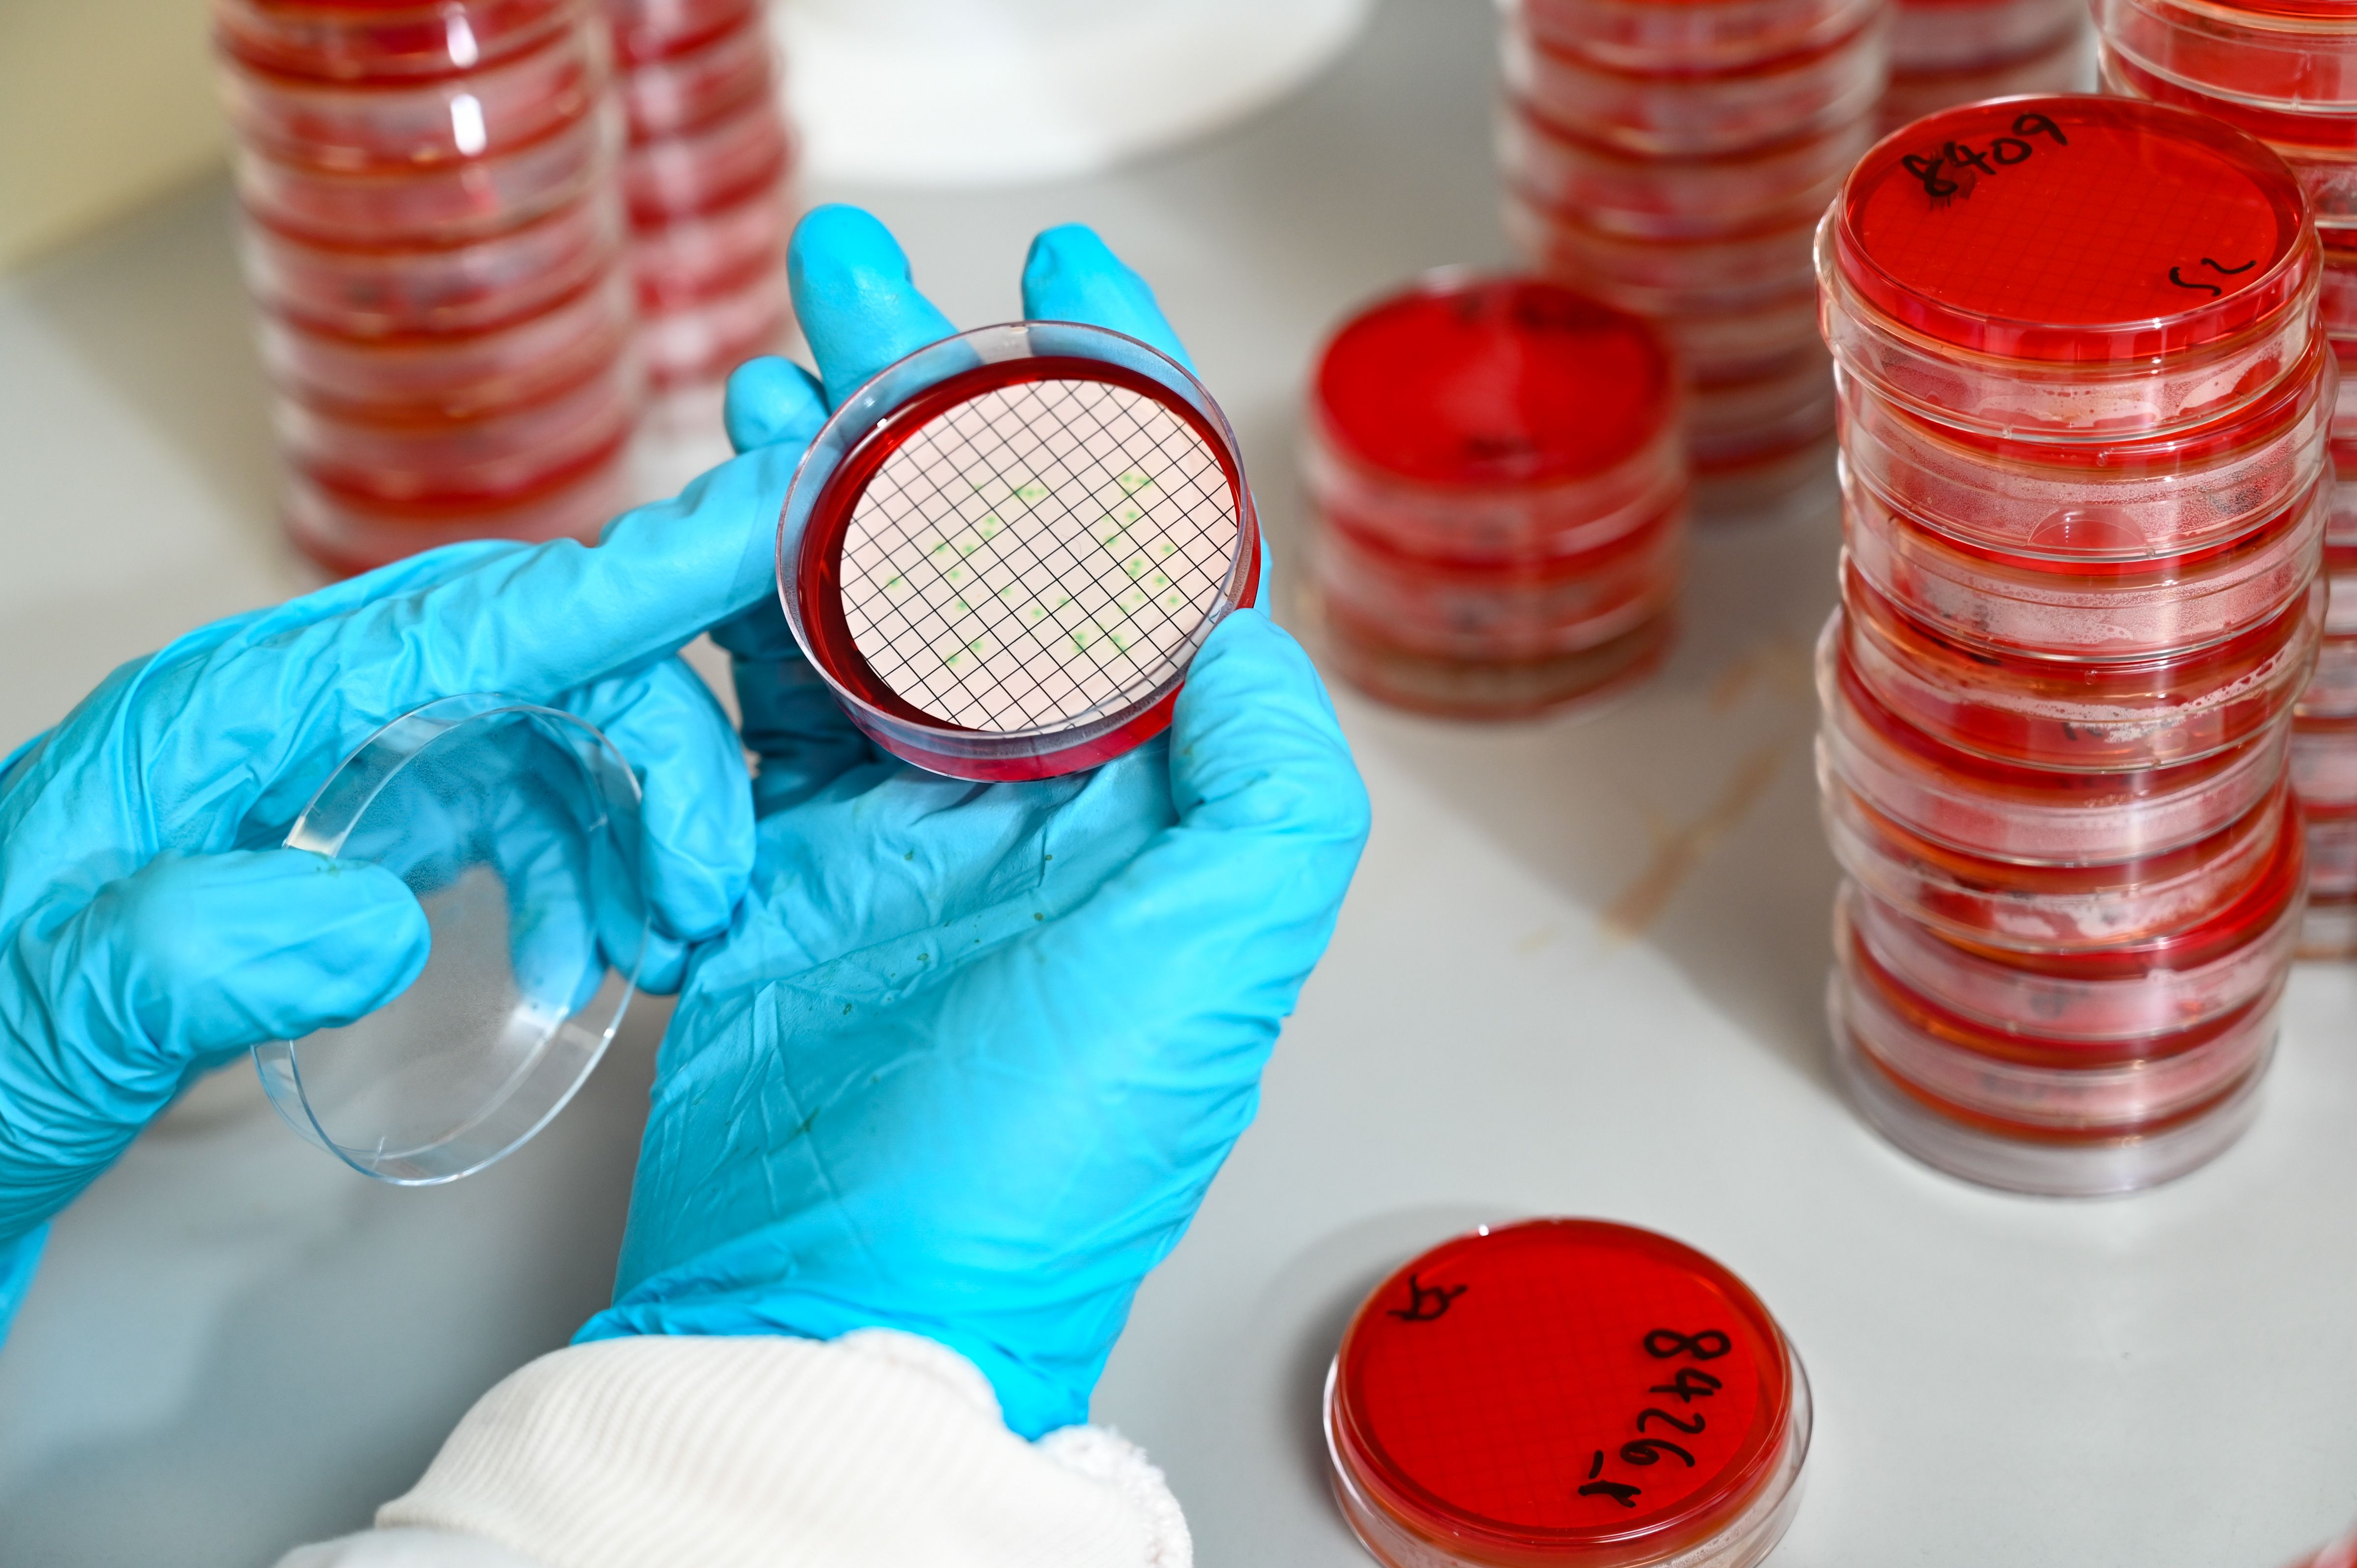

We are one of the UK’s leading providers of water testing services. Every year we carry out more than 1.25 million water tests in our laboratory in Farnborough, Hampshire.
Our experts provide a comprehensive range of microbiological and chemical testing services in our laboratory, which is UKAS-accredited to ISO 17025 and DWTS.
These services cover drinking water supplies, wastewater, recreational pools, environmental waters, legionella control and process water.
We deliver reliable, accurate analysis and high-quality data for commercial and private sector clients 365 days of the year. Clients include:
- water companies and water hygiene companies
- environmental consultants
- local authorities
- leisure facilities
- nursing homes
- individuals needing a private water supply test.
Dedicated account managers ensure we tailor our competitive services to your specific needs while first-class customer service comes as standard.
6 Steps to Peace of Mind
1. Get in touch
Contact us so that we can discuss your analytical and service requirements.
2. Tests
We can help you decide on the analysis you need.
3. Sampling
We can supply you with everything you need to do the job yourself. Or, we can do it on your behalf.
4. Logistics
Our drivers can deliver collect from your premises in our dedicated, tracked and temperature managed vehicles
5. Analysis
Our expert lab teams will test and report on your samples quickly and efficiently.
6. Advice
We'll help you interpret the results and let you know if they comply with regulatory limits.